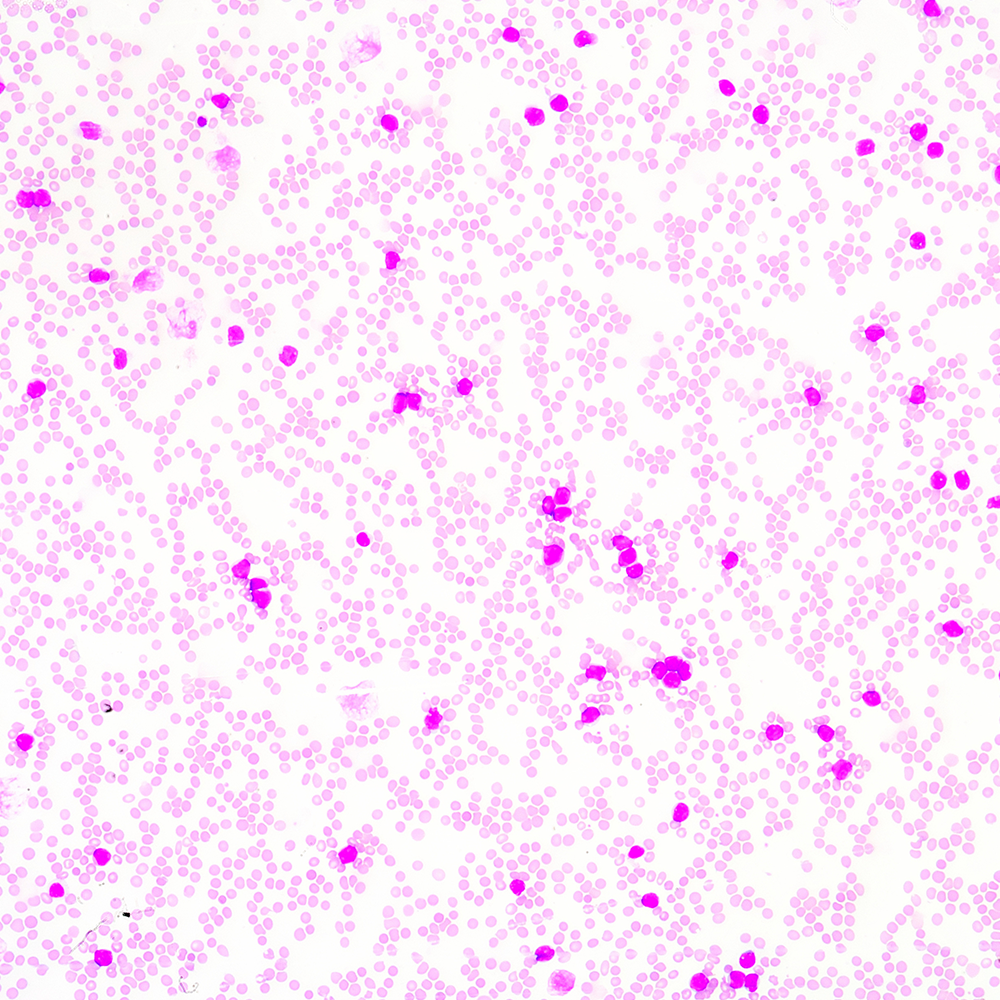
臺盼藍 VS AOPI：細胞活率計數，哪種染色更合你意？

博大博聚細胞計數分析系列:細分機型適配多場景,精準計數筑牢生物科研與產業根基
在生物科研、微生物發酵、免疫治療等領域,細胞計數精準度(活細胞比例、濃度重復性)直接影響實驗數據可靠性與生產穩定性,傳統儀器卻面臨 “功能固化適配少” 或 “通用機型計數失準” 的困境。博大博聚細胞計數分析系列以差異化機型矩陣覆蓋細胞、細菌、真菌、微藻、孢子等多數標本,每款機型均按標本特性優化硬件與算法,通過軟件識別標本形態精準區分活 / 死細胞,規避 “通用機型” 誤差,為細胞增殖研究、CAR-T 制備等場景提供支撐。未來,品牌將深耕標本特性與計數技術融合,以更全面產品矩陣賦能生物細胞學突破,注入 “數據動力”。